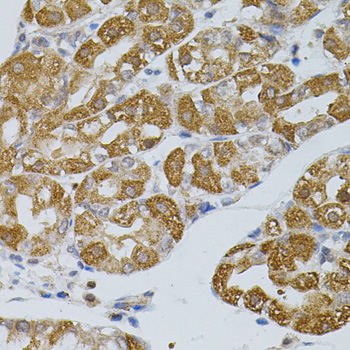
Immunohistochemistry - ASAH2 Polyclonal Antibody

-
Product Name
ASAH2 Polyclonal Antibody
- Documents
-
Description
Polyclonal antibody to ASAH2
-
Tested applications
WB, IHC
-
Species reactivity
Human, Mouse, Rat
-
Alternative names
ASAH2 antibody; BCDase antibody; HNAC1 antibody; LCDase antibody; N-CDase antibody; NCDase antibody; neutral ceramidase antibody
-
Isotype
Rabbit IgG
-
Preparation
Antigen: Recombinant protein of human ASAH2
-
Clonality
Polyclonal
-
Formulation
PBS with 0.02% sodium azide, 50% glycerol, pH7.3.
-
Storage instructions
Store at -20℃. Avoid freeze / thaw cycles.
-
Applications
WB 1:1000 - 1:2000
IHC 1:100 - 1:200 -
Validations

Immunohistochemistry - ASAH2 Polyclonal Antibody
Immunohistochemistry of paraffin-embedded mouse brain using ASAH2 antibody (40x lens).

Immunohistochemistry - ASAH2 Polyclonal Antibody
Immunohistochemistry of paraffin-embedded rat liver using ASAH2 antibody (40x lens).
Immunohistochemistry - ASAH2 Polyclonal Antibody
Immunohistochemistry of paraffin-embedded human stomach using ASAH2 antibody (40x lens).
-
Background
Plasma membrane ceramidase that hydrolyzes sphingolipid ceramides into sphingosine and free fatty acids at neutral pH. Ceramides, sphingosine, and its phosphorylated form sphingosine-1-phosphate are bioactive lipids that mediate cellular signaling pathways regulating several biological processes including cell proliferation, apoptosis and differentiation. Also catalyzes the reverse reaction allowing the synthesis of ceramides from fatty acids and sphingosine. Together with sphingomyelinase, participates in the production of sphingosine and sphingosine-1-phosphate from the degradation of sphingomyelin, a sphingolipid enriched in the plasma membrane of cells. Also participates in the hydrolysis of ceramides from the extracellular milieu allowing the production of sphingosine-1-phosphate inside and outside cells (By similarity). This is the case for instance with the digestion of dietary sphingolipids in the intestinal tract (By similarity).
Related Products / Services
Please note: All products are "FOR RESEARCH USE ONLY AND ARE NOT INTENDED FOR DIAGNOSTIC OR THERAPEUTIC USE"
